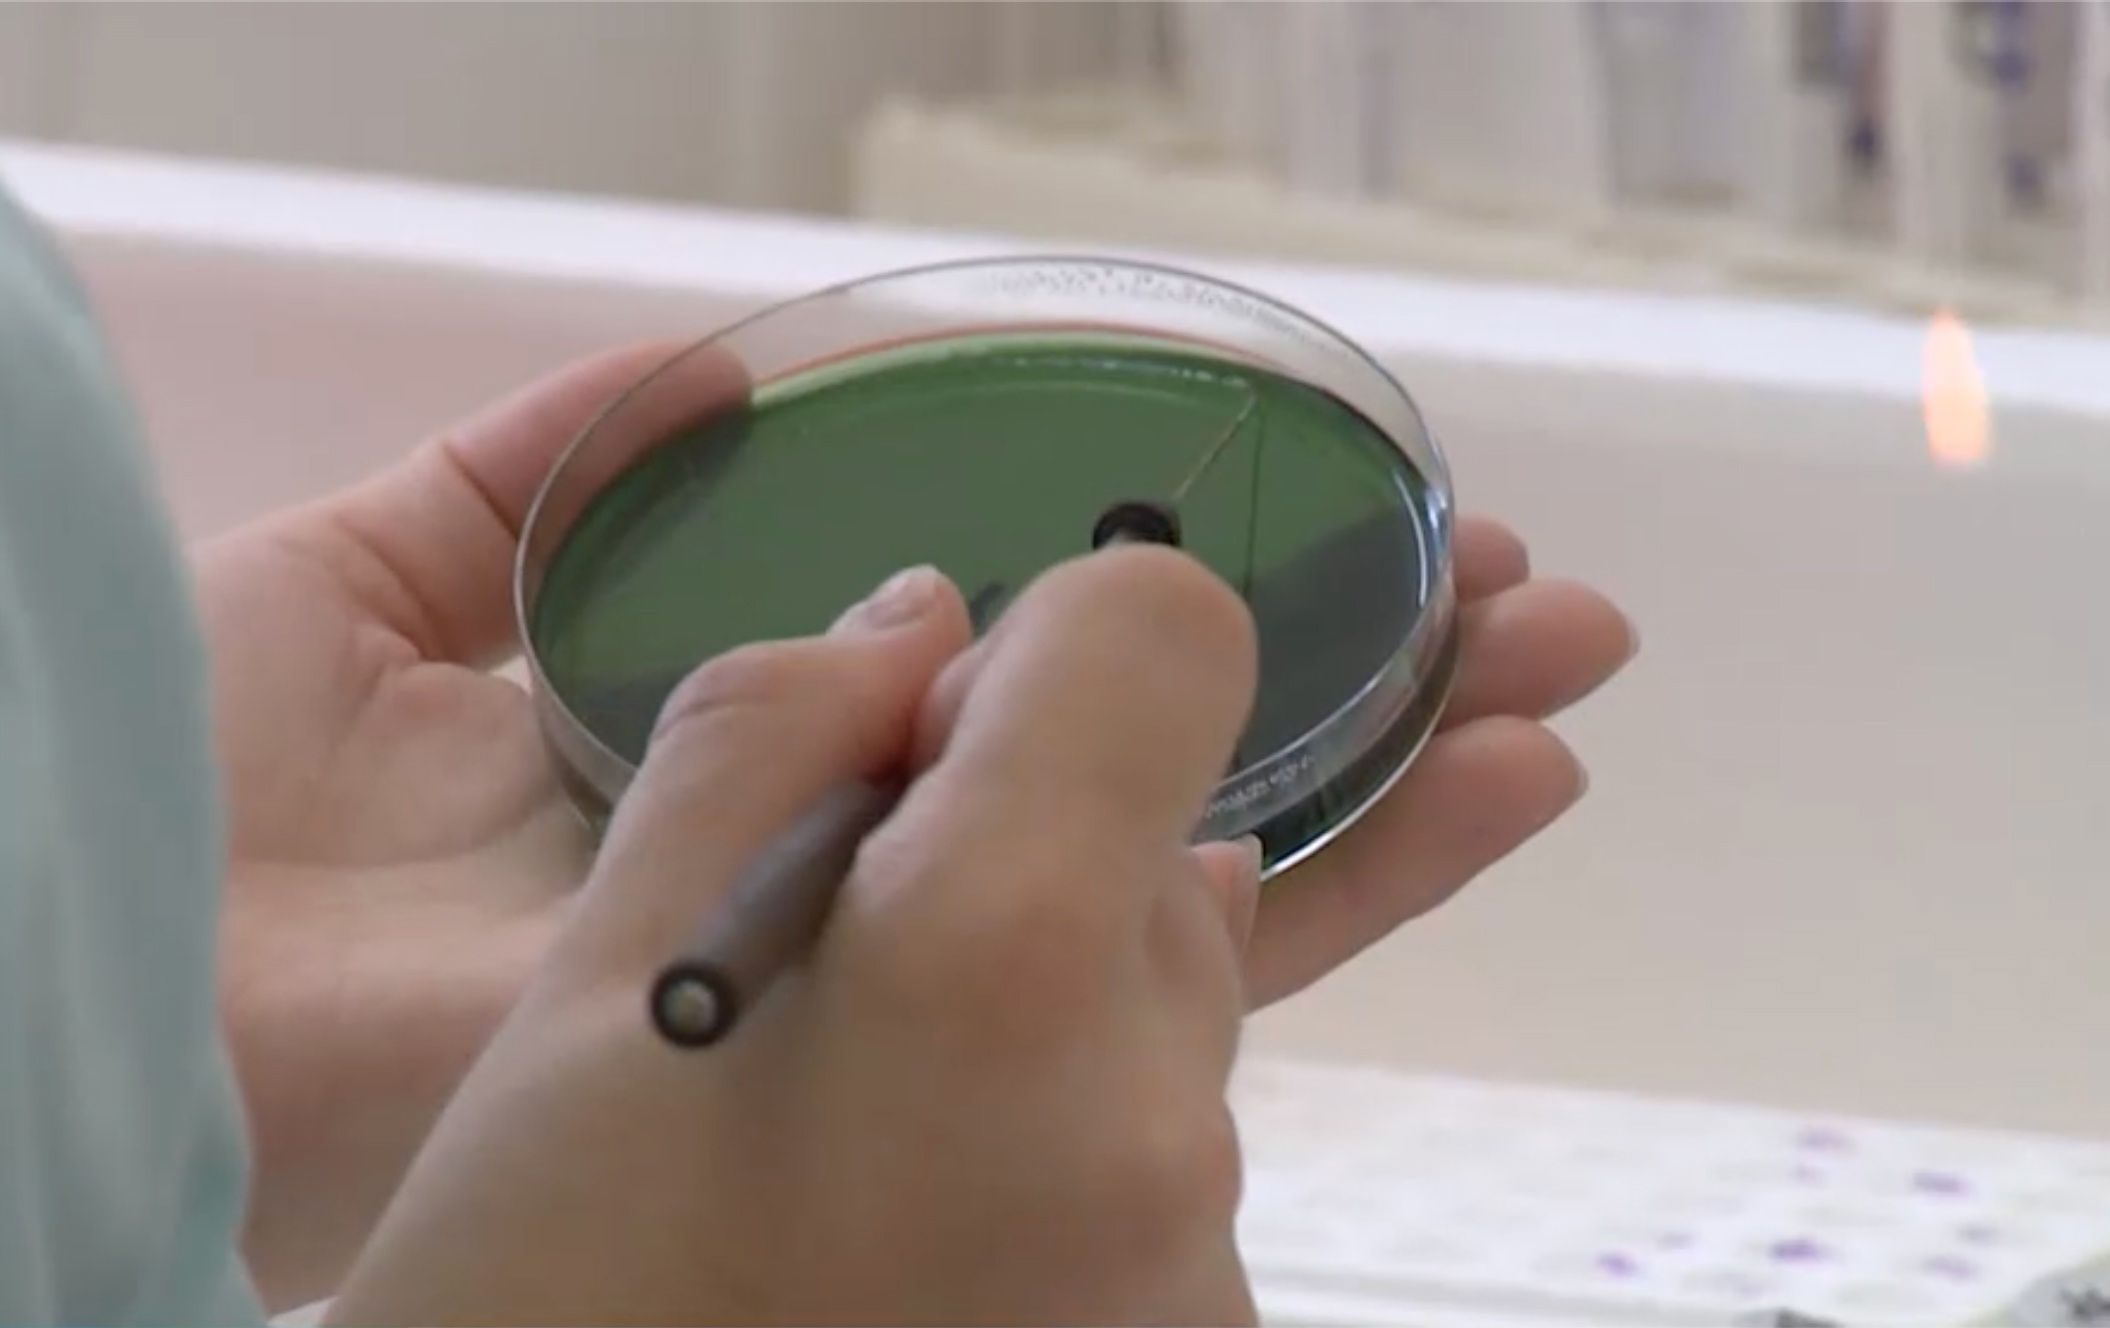

На основе исследований планируется разработка биологических добавок и лекарств, сообщили в паблике
Центра научных исследований 1XPEDITION.
Напомним, в 2019 году в Никоновой бухте острова Валаам дайверы обнаружили затонувший пароход «Valamon Luostari», который был изъят финскими войсками для нужд флота. В ходе нескольких экспедиций команда очистила заваленные конструкции и в прошлом году нашла в одном из помещений несколько запечатанных бутылок с молоком. Молоко пролежало под водой около 80 лет.
Ученые из петербургского НИИ имени Пастера заинтересовались этими бутылками. Один образец был доставлен в лабораторию, где выяснили, что холодная вода и отсутствие кислорода на дне Ладоги фактически законсервировали продукт.
Молоко свернулось, но не испортилось, — говорят ученые.

В то время уже использовалась пастеризация. Единственным признаком порчи был запах гнили, который исходил от самой бутылки.
Когда мы ее вскрыли, внутри такого отвратительного запаха не было. Разные люди воспринимали его по-разному, мне он больше казался как запах молочного сыра. Там не было каких-то изначально бактерий, которые могли бы привести к порче, не было грибов, наверное», – отметил старший научный сотрудник, руководитель группы метагеномных исследований НИИ эпидемиологии и микробиологии имени Пастера Дмитрий Полев.
Бактерии находились в состоянии анабиоза — они не погибли, а просто «заснули». Теперь их собираются заново выращивать в стерильных условиях. «Если мы выделим микробы полезные, то мы сможем изучить, что делает их полезными, какие гены отвечают за их полезные свойства, – отметила заведующая лабораторией медицинской бактериологии НИИ эпидемиологии и микробиологии имени Пастера Людмила Краева.
В планах ученых разработка биологических добавок и лекарств.
Фото: Центр научных исследований 1XPEDITION